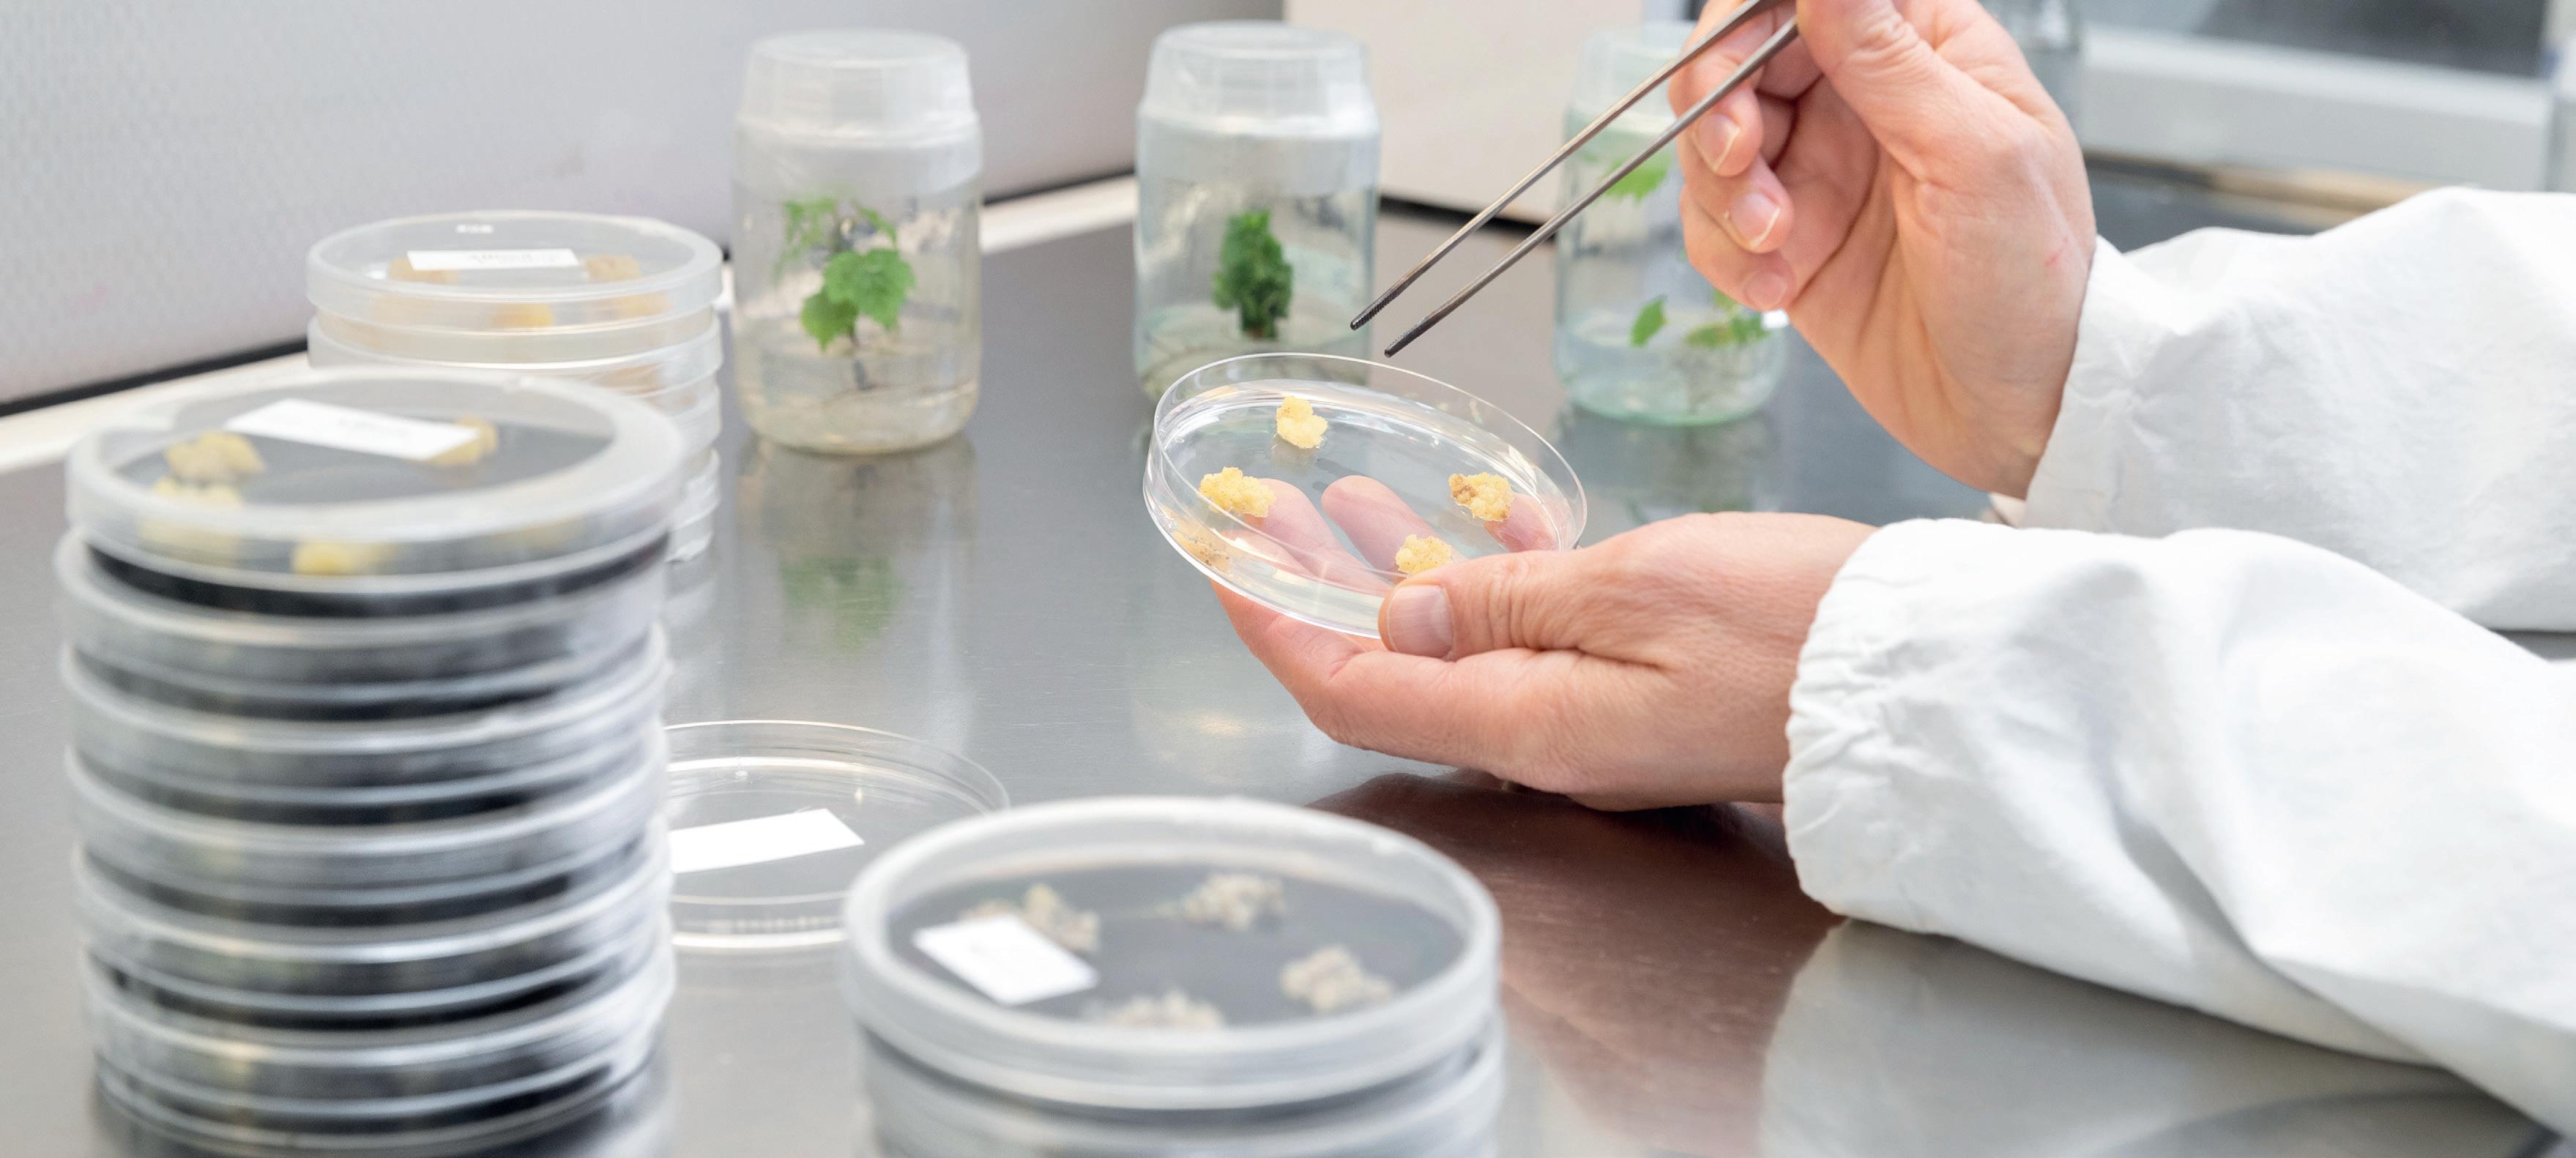

Periodico di cultura tecnico-scientifica della Fondazione Edmund Mach
Il triennio 2023-2025 vedrà la piena realizzazione delle iniziative FEM
Partita la sfida dei progetti PNRR
Lisa
Il
EDITORIALE

Verso il 150°
Mirco Maria Franco Cattani*
Nel 2024 la Fondazione
Mach festeggia un secolo e mezzo di vita. Una Storia che inizia il 12 gennaio 1874 quando la Dieta regionale tirolese di Innsbruck delibera di attivare a San Michele all’Adige una scuola agraria con annessa stazione sperimentale, ognuna delle quali con il compito di cooperare congiuntamente alla rinascita dell’agricoltura nel Tirolo. Un binomio indissolubile, quello tra ricerca e didattica, che dai tempi del fondatore e primo direttore Edmund Mach è stato sviluppato in specifiche attività tecniche, scientifiche e formative ininterrottamente dai suoi successori. E così, per quanto previsto dal proprio statuto, recentemente aggiornato e integrato, dovrà proseguire in futuro, per dare nuova linfa alla crescita del settore agricolo.
150 anni sono un traguardo importante, per un ente che è considerato una >> segue a pag. 2
si rivela al tempo stesso una grande sfida e una straordinaria opportunità. In questo insieme di riforme strutturali e investimenti, esso si declina in tre assi strategici attorno ai quali si articolano importanti progetti e interventi per promuovere uno sviluppo equo: digitalizzazione e innovazione, transizione ecologica, inclusione sociale.
>> segue a pag. 2
Incontro tra gli assessori Zanotelli e Protopapa e visita di una delegazione di AGRION
Trentino e Piemonte, sinergia sul contrasto alle fitopatie
Un ampio confronto sugli elementi di criticità del settore agricolo nei due territori, Piemonte e Trentino, per trovare insieme soluzioni e risposte, a partire dalle emergenze fitosanitarie per arrivare alle tecnologie digitali nella gestione sostenibile della risorsa idrica, al supporto del sostegno del reddito al settore zootecni-
co. È il tema al centro della recente visita alla Fondazione Mach nell’ambito della quale una delegazione della Regione Piemonte guidata dall’assessore all’agricoltura, cibo, caccia e pesca, Marco Protopapa, ha incontrato l’assessore provinciale, Giulia Zanotelli, alla presenza del presidente FEM, Mirco Maria Franco Cattani,
e del presidente di Agrion, Fondazione per la ricerca, l’innovazione e lo sviluppo tecnologico dell’agricoltura piemontese, Giacomo Ballari. Due giornate ricche di incontri e presentazioni che hanno coinvolto tecnici e ricercatori, rinsaldando una sinergia scientifica che anche in passato ha visto collaborare i due enti nel settore
agricolo, agroalimentare e ambientale. All’incontro, che si è svolto nella sala specchi dell’ex monastero agostiniano, hanno preso parte, tra gli altri, il dirigente del Dipartimento agricoltura della PAT, Romano Masè, il dirigente del Servizio Agricoltura e di APPAG della PAT, rispettivamente Andrea Merz e Pietro Molfetta, il direttore gene-
rale FEM Mario Del Grosso Destreri, il dirigente del Centro Trasferimento Tecnologico, Maurizio Bottura e in rappresentanza del Centro Ricerca e Innovazione, Claudio Ioriatti e Claudio Donati, accanto ai tecnici e funzionari di Agrion, della Regione Piemonte e della Provincia autonoma di Trento.

>> segue a pag. 2
Il 3 marzo si è svolto l’incontro dedicato agli alunni diplomati con la presentazione dell’Annuario
Si è svolta il 3 marzo scorso, alla Fondazione Edmund Mach, la cerimonia di consegna dei diplomi, tornata in presenza dopo due anni di stop dovuto al Covid-19. L’evento, dedicato a 188 studenti diplomati, ha visto intervenire l’assessore provinciale all’istruzione, Mirko Bisesti, l’attore trentino Andrea Castelli, il sindaco di San Michele, Clelia Sandri, il direttore generale FEM, Mario Del Grosso Destreri e il dirigente prof. Manuel Penasa. Durante l’evento, moderato dalla professoressa Martina Facchinelli, è stato presentato l’Annuario del Centro Istruzione e Formazione, il volume che raccoglie le numerose esperienze della comunità scolastica di San Michele. Andrea Castelli ha ricordato i momenti più intensi vissuti tra i banchi, facendo sorridere ma anche riflettere sul ruolo >> segue a pag. 3

16 Marzo 2023
Rizzetto
PNRR
e fauna d’acqua dolce SPECIALE ALL’INTERNO
FEM
L’assessore Bisesti: “Siate orgogliosi della storia di questo ente”
Silvia Ceschini
>> segue da pag. 1
delle principali istituzioni italiane attive nel campo dell’istruzione, della ricerca, della tecnologia, della sperimentazione, dell’assistenza in agricoltura e del trasferimento tecnologico nel settore agroalimentare e ambientale.
Per celebrare questo importante avvenimento il comitato organizzatore ha deciso di promuovere una serie di eventi e di iniziative che si concretizzeranno in particolare in convegni di
EDITORIALE
carattere scientifico su temi di attuale interesse attinenti al settore primario.

Il filo conduttore delle iniziative legate al 150° sarà la valorizzazione della storia dell’Istituto, il suo rapporto con il territorio e la comunità trentina, nell’ambito di un percorso che in questi decenni, a cavallo tra innovazione e tradizione, è stato accompagnato da un incessante processo di crescita e di internazionalizzazione. Allo stesso tempo le celebrazioni rappresenteranno anche l’occasione per una opportuna riflessione sulle traiettorie future della Fondazione.
Infatti oggi FEM svolge un ruolo particolare nel contesto scientifico nazionale e internazionale. Sta crescendo la performance qualitativa della ricerca
come attestato dall’incremento dell’impact factor delle pubblicazioni scientifiche e delle prestigiose collaborazioni con università ed enti affini presenti in 300 paesi di tutto il mondo. Anche la recente valutazione ANVUR attesta la competitività dell’ente trentino, facendone un riferimento autorevole nella produzione di conoscenza e di concrete ricadute per il territorio locale e nazionale, con ricercatori di notevole caratura che si avvalgono di una dotazione strumentale di primo livello. Una triangolazione equilatera perfetta: gli altri due angoli sono costituiti dal Centro Trasferimento Tecnologico e dal Centro Istruzione e Formazione. Anche per queste attività i numeri e i risultati prodotti sono no -
Trentino e Piemonte, sinergia sulle fitopatie
tevoli e significativi; oltre mille aziende clienti in Italia e all’estero, più di 15 mila utenti registrati alla piattaforma per la formazione e la messaggistica tecnica, oltre 450 mila mail inviate al mondo agricolo, più di 3000 partecipanti ai corsi di aggiornamento per frutticoltori, tanto per citarne alcuni. Non ultima la scuola, luogo di formazione e di educazione delle nuove generazioni per metterle alla guida del cambiamento. Un istituto che ha contribuito e contribuisce tuttora alla diffusione della cultura tecnica agraria formando professionisti affermati a livello internazionale, in grado di affrontare le sfide di oggi e creare un modo differente di pensare al futuro.
Il triennio 2023-2025 vedrà la piena realizzazione delle iniziative FEM
Partita la sfida dei progetti PNRR
FEM, grazie alla propria rete ed alle consolidate e riconosciute competenze, professionalità ed infrastrutture di ricerca ha promosso la propria partecipazione a varie iniziative legate al PNRR. La Fondazione Mach sarà parte attiva del “Centro Nazionale per lo sviluppo delle nuove tecnologie in agricoltura (Agritech)”, un progetto basato sull’utilizzo delle tecnologie abilitanti per lo sviluppo sostenibile delle produzioni agroalimentari.
In quanto socio fondatore, contribuirà al miglioramento delle produzioni attraverso il miglioramento genetico delle colture in risposta a nuove emergenze sanitarie, ai cambiamenti climatici e agli stress correlati, e all’esplorazione
delle risorse genetiche disponibili per lo sviluppo di nuove varietà resilienti e adattabili ai cambiamenti.
All’interno del “National Biodiversity Future Center”, il cui obiettivo è promuovere la gestione sostenibile dei servizi ecosistemici al fine di contrastare l’impatto antropico e degli effetti dei cambiamenti climatici, FEM farà uso di approcci innovativi per lo studio e la conservazione della biodiversità in ambito alpino, dagli ecosistemi lacustri e fluviali alle foreste e al suolo, dagli invertebrati ai piccoli e grandi mammiferi. Il consorzio “Interconnected Nord-Est Innovation Ecosystem” è finalizzato ad estendere i benefici delle tecnologie digitali alle principali aree di specializzazione del Nord-Est, dalla manifattura, all’agroalimentare, all’edilizia, al turismo, alla cultura.
L’ente di San Michele porta le proprie competenze per promuovere la digitalizzazione delle pratiche agronomiche, nonché la sostenibilità delle filiere agro-alimentari dei territori di montagna nell’ottica dell’economia circolare. Il Partenariato Esteso “Research and innovation network on food and nutrition: Sustainability, Safety and Security – Working ON Foods” lavorerà in modo sinergico per sviluppare e validare strategie per promuovere un modello di alimentazione sostenibile.
FEM, socio fondatore, svilupperà nuove tecnologie per la sicurezza e la qualità degli alimenti, per la generazione di nuovi alimenti funzionali e la verifica della loro qualità e accettabilità da parte del consumatore. La Fondazione è, inoltre, partner di un progetto volto a valutare l’effetto della somministrazione di glucorafina, un glucosinolato presente nei broccoli e cavolfiori, in particolare nei giovani germogli, nel trattamento di malattie neurodegenerative; supporterà anche realtà locali in due progetti volti alla rigenerazione di siti parte del patrimonio culturale e rurale. Infine, le competenze degli esperti di San Michele saranno rese disponibili anche a favore di ulteriori opportunità legate al PNRR.
>> segue da pag. 1
L’assessore Giulia Zanotelli ha illustrato le tematiche principali sulle quali la Provincia è impegnata anche con il supporto di FEM. A cominciare dalla lotta alle fitopatie, in particolare la flavescenza, gli scopazzi e la cimice, per arrivare ai rinnovi varietali, alla gestione sostenibile della risorsa idrica con l’aiuto della tecnologia, al grande tema dei cambiamenti climatici. Infine, le grandi partite del bostrico post Vaia e il supporto alla zootecnia. Un approfondimento specifico è stato rivolto anche al tema centrale dell’attivazione della nuova PAC 2023 –2027, dopo l’approvazione del PSP nazionale, a partire da alcune criticità che richiederanno, già a partire dalle prossime settimane, un lavoro congiunto delle strutture tecniche, finalizzato ad individuare possibili soluzioni condivise da porre all’attenzione della Commissione Politiche Agricole e dei competenti organi ministeriali. È seguito con funzionari e operatori di settore un tavolo di lavoro tecnico che ha gettato le basi per il potenziamento delle forme di collaborazione già da tempo attivate.
Due progetti a supporto del territorio
Oltre all’ambito della ricerca i fondi del PNRR supporteranno interventi mirati della Fondazione a beneficio delle realtà del territorio, nello specifico due progetti della Misura 1 volti ad aumentare l’attrattività dei beni culturali ed ambientali del Trentino.
Nel Bando “Orti e Giardini Storici”, coordinato dal Castello del Buonconsiglio, FEM collaborerà al recupero dell’Orto Veneggia Rossa presso il maniero di Castel Thun. Un coinvolgimento che prevede l’analisi di stabilità del patrimonio arboreo presente nel sito ed una sua mappatura digitale; una analisi dei pollini insistenti nell’area del castello; indicazioni di tipo agronomico e forestale per la messa a dimora di specie orticole, erbacee e forestali ed un supporto nella creazione di nuovo materiale didattico.

All’interno del “Bando Borghi”, il cui capofila è il comune di Pellizzano, esperti e studenti di FEM saranno coinvolti nella progettazione di un anfiteatro vegetale e nel recupero per la messa a produzione di alcuni ettari di terreno posti nei terrazzamenti a monte del borgo di Termenago, andando ad ampliare l’offerta produttiva del settore agricolo locale.

02
>> segue da pag. 1
* Presidente FEM
Alessandro Gretter
Dai giardini storici al recupero dei terreni
Il ruolo degli psicobiotici nello studio coordinato da University College Cork
Una dieta mirata per ridurre stress e ansia
Sono promettenti i risultati di un innovativo studio internazionale coordinato dallo University College Cork e che vede tra i partner l’Unità di Ricerca Metabolomica FEM, che dimostrerebbe come la combinazione virtuosa di stile di vita e alimentazione potrebbe incidere anche sulla salute mentale delle persone.
“Feed your head” cantava una nota band americana nel 1967, riferendosi alla capacità di alcune sostanze di stimolare l’attività cerebrale. Nello studio FEM non si fa riferimento alla controcultura di fine anni Sessanta, ma si dimostra come la sinergia di specifici alimenti e abitudini di vita possa contribuire positivamente anche
Andrea Anesi, Fulvio Mattivi, Floriana Marin
su sindromi mentali quali depressione, Alzheimer, autismo o disturbi da stress.
La ricerca esamina il consumo di cibi fermentati e fibre vegetali in somministrazioni ripetute lungo l’arco della giornata e per un periodo medio-lungo (4 settimane). Una dieta variata che include ingredienti come cavoli, porri, cipolla ed aglio, mele, banane e piccoli frutti, cereali integrali, legumi e cibi fermentati come crauti, yoghurt e kefir favorisce infatti lo sviluppo nel microbiota dei microorganismi psicobiotici. Nei laboratori dell’Unità di Metabolomica sono stati analizzati i biofluidi umani (plasma e urine) per la quantificazione mirata dei cataboliti di aminoacidi

essenziali e dei metaboliti sintetizzati dal microbiota intestinale. Confrontando due campioni di studio, uno caratterizzato dal consumo di una dieta con le caratteristiche sopra evidenziate e l’altro dal consumo di una dieta convenzionale, al termine delle quattro settimane di osservazione il primo
gruppo ha segnalato una riduzione dello stress percepito rispetto ai componenti del secondo gruppo associato ad una dieta standard. Il lavoro segna un importante punto di partenza per ulteriori approfondimenti sulle potenzialità di diete mirate al trattamento dei disturbi mentali.
3a edizione della giornata tecnica dedicata a Trentino, Nord-Italia e Slovenia
Olive, focus su produzione e prospettive

Si è svolta lo scorso 2 febbraio la terza edizione della giornata tecnica olivicola rivolta a operatori e tecnici organizzata da FEM in collaborazione con l’Università di Verona, l’Agenzia Regionale per lo Sviluppo Rurale del Friuli Venezia Giulia e l’Istituto Agrario e Forestale di Nova Gorica in Slovenia. I temi trattati hanno riguardato la mosca dell’olivo, osservando come negli ultimi anni gli evidenti cambiamenti climatici, con l’aumento della frequenza di inverni miti e poco piovosi, favoriscono lo svernamento di popolazioni elevate della mosca dell’olivo, tra gli inset-

Supercomputer per gestire il territorio
Daniele Marinelli e Davide Andreatta
Monitorare gli ecosistemi dallo spazio per sviluppare migliori interventi e politiche di gestione del territorio. Questa è la sfida che ha impegnato l’Unità di ecologia forestale del Centro Ricerca e Innovazione nel progetto europeo Highlander. In particolare, sono state sviluppate due applicazioni: uno strumento di mappatura dei danni da insetti in foresta e uno strumento per la stima della frequenza di taglio dei prati. Dopo la tempesta Vaia, l’infestazione di bostrico è arrivata ad attaccare 8000 ettari a fine 2022. È quindi urgente misurare l’impatto di questi eventi e identificare con tempismo nuovi cambiamenti. In questo ambito, i satelliti Sentinel-2 dell’Agenzia Spaziale Europea “fotografano” dallo spazio l’intero Trentino ogni 5 giorni e possono essere utilizzati per un monitoraggio continuo nel tempo e su tutto il territorio. Lo strumento sviluppato identifica le infestazioni di bostrico utilizzando queste immagini satellitari. L’applicazione analizza le variazioni nel tempo della superficie forestale allo scopo di identificare le zone con presenza di stress della vegetazione, che può essere associata ad un infestazione di bostrico. Il risultato di questa analisi è una mappa che identifica non solo le infestazioni passate, per stimare i danni totali, ma anche i nuovi attacchi. Il secondo strumento sviluppato nell’ambito del progetto utilizza lo stesso tipo di immagini per stimare il numero di tagli effettuato sui prati in un anno. La frequenza di taglio è, infatti, un fattore determinante per la composizione floristica dei prati e può essere utilizzato come indicatore di pregio floristico-faunistico, di rischio di abbandono e di inquinamento da nitrati. L’algoritmo proposto apre, inoltre, a nuove opportunità nella verifica delle condizionalità dei premi attribuiti dal Piano di Sviluppo Rurale e nella definizione di politiche e incentivi per i prati.
Michele Morten
ti più temuti dall’olivicoltore. Nel 2022, l’estate molto calda e un’attenta strategia di gestione dell’insetto hanno aiutato a frenare lo sviluppo della mosca, che in primavera era iniziato in modo aggressivo. Gli olivicoltori, infatti, seguendo le indicazioni tecniche di FEM, dal 2020 hanno utilizzato la tecnica della cattura massale su ampie superfici, come prima esperienza in Italia, confermando l’importanza di adottare tale strategia già dai mesi primaverili.
Altro importante aspetto trattato ha riguardato l’alternanza di produzione, che si è manifestata in maniera
significativa negli ultimi anni con picchi di elevate e basse produzioni non conosciute in passato. FEM sta studiando questo fenomeno per capire le cause e per poterle contrastare con pratiche agronomiche adeguate, tra
cui la potatura, che dalle prime sperimentazioni sembra giocare un ruolo rilevante. Hanno completato il programma della giornata due relazioni sulla gestione delle tignole rodiscorza e dell’occhio di pavone.
Scopazzi del melo, importanti gli estirpi
Matteo de Concini
La 26^ giornata frutticola organizzata dal Centro Trasferimento Tecnologico in collaborazione con i consorzi Melinda, La Trentina e APOT si è svolta, il 1° marzo a Cles, con oltre 400 partecipanti tra presenti in sala e in diretta web. Il principale tema affrontato ha riguardato gli scopazzi del melo, fenomeno che nel corso degli anni ha visto un’evoluzione dell’incidenza sul territorio. Il monitoraggio statistico provinciale effettuato da FEM in collaborazione con APOT ha permesso di controllare circa 760.000 piante per un totale di 210 ettari.
Attualmente la malattia ha raggiunto percentuali preoccupanti di presenza, arrivando lo scorso anno ad una media di piante colpite dell’1,54%.
>> segue da pag. 1
fondamentale della scuola. Infine, la premiazione delle eccellenze e il lancio dei cappellini da parte dei nuovi diplomati.
L’assessore Bisesti ha evidenziato che la FEM è un ente che con le sue attività e i suoi quasi 150 anni di storia “ci rende orgogliosi”. E rivolgendosi agli studenti ha sottolineato: “Il Trentino è una terra che sa dare tanto e voi rappresentate una istituzione che è un unicum. Fate parte di questa storia; voi uscite, ma sapete che c’è una porta aperta, in un territorio che può fare la differenza, grazie a voi e al percorso che avete fatto fino ad oggi e che farete domani”.
Durante l’evento sono state illustrate le azioni per il contenimento degli scopazzi, che vanno condotte con attenzione e precisione a partire dall’estirpo di tutte le piante colpite. Per il controllo degli insetti in grado di trasmettere la malattia è necessario seguire le indicazioni proposte dal servizio di consulenza FEM nelle singole zone frutticole. Sono stati inoltre illustrati gli studi sugli insetti vettori svolti negli ultimi anni: oltre alle note psille (C. melanoneura e C. picta) sono in corso valutazioni su nuovi possibili insetti in grado di acquisire e trasmettere il fitoplasma.
Il Centro Ricerca e Innovazione della Fondazione Edmund Mach ha descritto gli studi sugli aspetti molecolari della malattia che potranno in un prossimo futuro offrire nuove soluzioni per il contenimento degli scopazzi, tra cui l’utilizzo di portinnesti resistenti. È stato anche riportato il quadro della problematica in Alto Adige e APOT, evidenziando le azioni promosse dai produttori per il contenimento della malattia. Infine, attraverso la presentazione dell’attività sperimentale di campo condotta negli ultimi anni, sono state descritte le migliori tecniche di produzione delle nuove varietà di melo piantumate sul territorio provinciale.
03
L’assessore Bisesti: “Siate orgogliosi della storia di questo ente”
Wintersporttag, FEM sul podio La lezione del prof. Basso
Il ruolo della tecnologia digitale in agricoltura è il tema affrontato alla FEM il 27 febbraio scorso, nell’ambito del seminario tenuto dall’esperto prof. Bruno Basso. A circa 130 persone in presenza e collegate, il professore di Scienze della Terra e dell’Ambiente presso la Michigan State University ha parlato del ruolo della tecnologia digitale in agricoltura con esempi di possibili e concrete applicazioni in campo.

Il ricordo di Gabriele Calliari
Profondo cordoglio per la scomparsa di Gabriele Calliari, ex vicepresidente dell’Istituto Agrario prima e della FEM dopo. La sua attività nel consiglio di amministrazione è durata 16 anni, dal 2001 al 2017. Calliari nel suo ruolo di amministratore ha seguito da vicino le vicissitudini e le profonde trasformazioni dell’ente in un percorso a cavallo di importanti cambiamenti dell’agricoltura e delle sensibilità ambientali.

Wintersporttag, il campionato degli sport invernali dell’Euregio che coinvolge da 30 anni le scuole agrarie del Trentino, Alto Adige e Tirolo, e svoltosi quest’anno a Sankt Johann, ha visto salire sul podio sei studenti FEM. I ragazzi si sono classificati nelle prime tre posizioni nelle specialità sci fondo, snowboard e sci alpino, mentre nella graduatoria dei gruppi la FEM ha conquistato il 3° posto su 10 scuole in gara.

Gestioni a confronto
Gestione biologica e integrata a confronto, nei giorni scorsi, alla FEM dove i tecnologi del Centro Trasferimento Tecnologico hanno illustrato ad una cinquantina di tecnici del settore vitivinicolo ed enologi delle cantine trentine i risultati di una sperimentazione durata oltre dieci anni nel campus. Dallo studio è emerso che la gestione biologica fornisce risultati produttivi e sanitari comparabili alla gestione integrata.

FEM SUL TERRITORIO
Un viaggio tra manifestazioni e rassegne
La Fondazione Mach è attivamente impegnata nell’organizzare la propria presenza all’interno delle grandi manifestazioni programmate sul territorio, ma anche fuori provincia.
Il 18 e 19 marzo si è svolta a Trento la Mostra dell’Agricoltura, dove nello stando congiunto con PAT e Trentino Marketing FEM ha proposto una serie di attività dimostrative sui temi clima, suolo, acqua e nuove tecnologie, mentre nel polo zootecnico gli studenti hanno svolto attività didattica illustrando le caratteristiche degli animali presenti.

Dal 2 al 5 aprile va in scena Vinitaly e FEM sarà presente nell’area dedicata al Trentino, mentre il 22-23 aprile gli studenti saranno alla Festa di Primavera presso la sede della Federazione Allevatori. I giorni 1 e 2 maggio torna “Maggio a Cles” dove saranno presenti studenti e docen -
ti che proporranno una serie di degustazioni di prodotti da loro realizzati a base di carne, lattiero-caseari, vegetali, in abbinamento ai vini prodotti nella cantina didattica. In mostra ci saranno anche le nuove varietà di mele prodotte dal Centro Ricerca e Innovazione e i prodotti editoriali del Centro Trasferimento Tecnologico.

Si prosegue, il 6 e 7 maggio, con il Wired Next Fest Trentino, il nuovo festival che metterà in vetrina a Rovereto i tanti attori della ricerca e dell’innovazione trentina. E ci sarà anche la FEM all’interno di un palinsesto fitto di mostre, workshop interattivi e conferenze. Immancabile anche quest’anno la presenza, dal 25 al 28 maggio, al Festival dell’Economia di Trento con un incontro sui crediti di carbonio e il futuro dell’agricoltura.
Le Giornate Tematiche dell’indirizzo Gestione Ambiente Territorio
Alle numerose attività di collaborazione tra la scuola e gli altri centri della FEM, negli ultimi anni si sono aggiunte le “Giornate tematiche” promosse dall’articolazione Gestione Ambiente e Territorio e ormai entrate a pieno titolo nella pratica didattica. Ispirandosi alle emergenze di stringente attualità, i docenti dell’area tecnico-pratico individuano una tematica di particolare interesse e organizzano un workshop in cui le classi dialogano con ricercatori e tecnici FEM ed esperti esterni. Seguono gli appuntamenti dell’ultimo anno solare. “Gli scolitidi tra cambiamenti climatici e interventi selvicolturali”: con esperti del Centro Trasferimento Tecnologico, della Provincia autonoma di Trento, dell’Università di Padova, della Provincia autonoma di Bolzano e del Comune di Levico. Sono state presentate le strategie gestionali dei boschi bostricati e le prospettive future, la biologia e la dinamica di popolazione attuale nel triveneto, la gestione dei boschi altoatesini e nel comune di Levico.
11 lezioni per conoscere le api
La FEM ha avviato un corso teorico-pratico di apicoltura. Si tratta di 11 lezioni che si svolgeranno fino al 6 luglio, per un totale di 32 ore, nella sede periferica a Casalino di Pergine Valsugana.
Il corso, organizzato dal Centro Trasferimento Tecnologico, è rivolto a coloro che sono interessati a conoscere a fondo le api e ad intraprendere l’attività apistica a livello familiare/ hobbistico, ma anche agli apicoltori professionali già avviati.

Zanzare e malattie trasmesse
Si è svolto di recente l’incontro divulgativo promosso dalla cabina di regia provinciale per la sorveglianza e il controllo dei vettori di interesse medico-veterinario che al MUSE ha fatto il punto sulla situazione in Trentino. Rivolto ai cittadini e ai rappresentanti della pubblica amministrazione, l’incontro è stato l’occasione per un aggiornamento sulla situazione della diffusione, del controllo e delle prospettive portate dalla ricerca.
I NOSTRI OSPITI
Il periodo invernale non è forse il preferito per visitare un campus dove una parte importante del lavoro si rivolge alle applicazioni agricole; tuttavia, serre e laboratori ben rappresentano alcune attività significative svolte in questo ambito. Nei tre mesi novembre 2022 – gennaio 2023 hanno visitato i nostri spazi 11 gruppi, per un totale di 201 visitatori. Altre 7 visite (182 visitatori) hanno riguardato la sola azienda agricola. Delegazioni degne di nota sono state quelle del Macedonian Association of Agricultural Cooperatives, quella di Coop Italia – Assomela e quella della Fondazione per la ricerca, l’innovazione e lo sviluppo tecnologico dell’agricoltura piemontese (Agrion). Due università statali (Brescia e Milano) hanno accompagnato i loro studenti in visita ai laboratori che sviluppano il miglioramento genetico della vite e del melo.
PUBBLICAZIONI
“I grandi carnivori”: con ricercatori del Centro Ricerca e Innovazione ed esperti della Provincia autonoma di Trento. E’ stato illustrato come gestire queste specie tra prevenzione e danni e spiegato il monitoraggio genetico ed ecologico quale strumento della ricerca scientifica a supporto della coesistenza tra attività umane e grandi carnivori.

“Le specie aliene”: con ricercatori del Centro Ricerca e Innovazione, esperti del Centro Trasferimento Tecnologico, del Museo Civico di Rovereto e del Muse. Nel seminario è stato fornito il quadro generale e sono stati mostrati alcuni esempi di monitoraggio e gestione di animali e piante alloctone. Di grande rilevanza il valore formativo di queste esperienze: gli studenti si confrontano con personale altamente qualificato e specializzato, apprendono contenuti e tecniche aggiornati con i risultati più recenti e vivono in prima persona la virtuosa compenetrazione tra scuola, ricerca e mondo del lavoro.
Maggiori informazioni sulle pubblicazioni della FEM sono disponibili sul sito www.fmach.it/ Servizi-Generali/Editoria
04
Rubriche a cura dell’Ufficio Comunicazione e Relazioni Esterne
NEWS ED EVENTI Terra di Mach n. 16 - Marzo 2023
Rizzetto
E. Mach, San Michele all’Adige (TN); Via E. Mach 1 - ufficio.stampa@fmach.it - Progetto grafico e impaginazione IDESIA, Trento - Stampa Nuove Arti Grafiche, Trento - Registrazione Tribunale di Trento n. 1 del 02.03.2018
18
2023. LOGO FSC www.fmach.it
- Direttore responsabile Silvia Ceschini - Comitato redazione Erica Candioli, Silvia Ceschini, Emanuele Eccel, Martina Facchinelli, Claudio Ioriatti, Floriana Marin, Sergio Moser, Manuel Penasa, Mario Pezzotti - Hanno collaborato Davide Andreatta, Andrea Anesi, Mirco Maria Franco Cattani, Matteo de Concini, Martina Facchinelli, Alessandro Gretter, Floriana Marin, Daniele Marinelli, Fulvio Mattivi, Michele Morten,
Lisa
-
Fotografie Archivio FEM (Ufficio stampa, M. Festi, M. Parisi), Archivio Ufficio stampa PAT - Marco Simonini, Archivio Ufficio stampa Castello Buonconsiglio,- Direzione e Amministrazione Fondazione
- Chiuso in redazione
marzo
Martina Facchinelli
FEM e fauna d’acqua dolce
In questo inserto presentiamo le molteplici attività svolte da FEM sulla fauna d’acqua dolce: dall’allevamento dei pesci, soprattutto salmonidi, al monitoraggio degli invertebrati per arrivare allo studio della microfauna autoctona e aliena che popola laghi, fiumi e torrenti in Trentino.
Le attività vanno dalla consulenza e sperimentazione per la produzione di salmonidi di allevamento alle attività di ricerca sulle specie native e aliene, a partire dalla genetica, come strumento di gestione e conservazione, per giungere all’illustrazione delle attività di istruzione e formazione. Spazio anche ai progetti di ricerca e sperimentazione che puntano al miglioramento delle tecniche di allevamento dei salmonidi, ma anche alla loro qualità, al loro benessere, senza trascurare gli aspetti legati alla nutrizione. Nell’ottica di uno sviluppo ecosostenibile dell’acquacoltura non manca l’attenzione alle tecnologie di controllo avanzate degli allevamenti, dai monitoraggi real-time ai modelli previsionali e alla gestione di Big Data.
Consulenza e sperimentazione per migliorare le tecniche di allevamento, la sostenibilità della filiera e la qualità del prodotto
Un centro ittico d’avanguardia a supporto dell’acquacoltura trentina
Il cuore dell’attività del Centro Trasferimento Tecnologico in questo ambito è rappresentato dal centro ittico FEM. Costituito ad inizio anni Novanta del secolo scorso quale supporto scientifico alla produzione salmonicola locale, oggi è una moderna struttura dove si studiano le specie ittiche di interesse per il territorio, con particolare attenzione a quelle destinate all’acquacoltura.
La sua attività è finalizzata allo studio e miglioramento delle tecniche di allevamento delle specie d’acqua dolce di interesse per il settore, con particolare attenzione a nutrizione e benessere animale, buone pratiche gestionali, sostenibilità della filiera e qualità del prodotto ittico.
Il centro ittico dispone di più di 100 vasche, la maggior parte collocate in una struttura coperta di 800 mq, 66 delle quali sono specificamente dedicate alla sperimentazione ed alcune ottimizzate per i test nutrizionali. Tutte le vasche possiedono un approvvigionamento idrico che permette di standardizzare ed ottimizzare le condizioni di allevamento.
L’impianto dispone inoltre di un locale per l’incubazione delle uova e lo svezzamento del novellame e anche di piccoli sistemi di allevamento a ricircolo, in cui l’utilizzo d’acqua è ridotto fino al 90% ed è possibile il controllo della temperatura di allevamento indipendentemente dalla stagione. La modularità dei singoli settori dell’impianto e la tipologia delle vasche consentono di effettuare sia sperimentazioni su piccoli lotti di materiale ittico come anche la produzione di grandi quantitavi destinati alla vendita. Il centro ittico produce mediamente 10 tonnellate all’anno di trota iridea selezionata che viene venduta all’interno del circuito dell’Associazione dei Troticoltori Trentini.

Le dimensioni e la potenzialità di eseguire più prove sperimentali contemporaneamente permettono al centro di fungere da piattaforma tecnologica per Università, Istituti di ricerca e aziende che non possiedono strutture adeguate alla sperimentazione. Il centro svolge anche attività di consulenza nell’ambito della troticoltura; in accordo con
l’Organizzazione dei Produttori ASTRO vengono svolti per una sessantina di siti produttivi servizi che vanno dalla sorveglianza sanitaria ai monitoraggi ambientali. Stretta è anche la collaborazione con l’industria, soprattutto nella filiera produttiva dei mangimi di acquacoltura; il centro fornisce il suo supporto scientifico per lo sviluppo e la sperimentazione di nuovi prodotti destinati all’alimentazione del pesce. L’Unità acquacoltura e idrobiologia del Centro Trasferimento Tecnologico è impegnata da anni nel monitoraggio delle specie aliene degli ambienti acquatici. Nel Lago di Garda, dal 2008 ad oggi, sono state segnalate diverse specie di molluschi alieni.
In concomitanza con il monitoraggio della specie di gambero di fiume autoctono è stata fatta la prima segnalazione della specie alloctona Gambero rosso della Luisiana nel lago di Lagolo. È stato, inoltre, fatto il punto delle specie ittiche alloctone nei laghi trentini, così come sulla diffusione della medusa d’acqua dolce.
Le attività di ricerca e innovazione volte alla conservazione, studio e ripristino della fauna d’acqua dolce
Specie native e aliene sotto la lente della ricerca
La Fondazione Edmund Mach studia la diversità e la consistenza delle popolazioni residue di specie ittiche endemiche alpine a rischio di estinzione e di rilevante interesse sia conservazionistico che socioeconomico. Specie come la Trota marmorata, il Luccio italico, il Temolo adriatico, hanno subito un marcato declino a seguito di numerosi impatti antropici. Tra questi, la pratica consolidata di introdurre linee
esotiche – a sostegno delle attività alieutiche – ha fortemente rarefatto le popolazioni residue, originando il problema dell’ibridazione genetica. Gli studi vengono svolti dall’Unità di Genomica della Conservazione del Centro Ricerca e Innovazione. In collaborazione con Associazioni di pesca e Enti locali, responsabili della gestione, lo strumento della genetica è utilizzato per definire le corrette
unità gestionali, ovvero le linee genetiche più o meno differenziate e meritevoli di conservazione, per monitorarne lo stato delle popolazioni, la numerosità degli individui non introgressi e il loro eventuale grado di consanguineità, e per orientare infine le attività di gestione, ripristino e conservazione, suggerendo sia misure attive (supporto alle attività di riproduzione artificiale e ripopolamento) che passi -
ve (indicazioni sulle modalità e regolamentazioni del prelievo alieutico).
Sempre al Centro Ricerca e Innovazione la fauna acquatica è oggetto di studio da parte dell’Unità di Idrobiologia che analizza la biodiversità delle acque interne nell’area alpina e subalpina, con focus su specie di particolare interesse conservazionistico. I ricercatori hanno definito e stanno implementando attività di conservazione delle popolazio-
ni di gambero di fiume per le quali l’invasione di gamberi alieni di origine americana, portatori della peste del gambero, rappresenta una delle minacce principali. In Trentino sono presenti due specie di origine americana, il gambero rosso della Louisiana e il gambero americano, per le quali i ricercatori FEM stanno conducendo campagne di rimozione (del 2018 al lago di Lagolo, nel 2023 nel lago Costa) e di identificazione dei patogeni.
Nelle acque del lago di Garda, a partire dagli anni Settanta, è stato registrato l’arrivo di numerose specie invasive. Nel 2022 i ricercatori della FEM hanno individuato un mollusco bivalve originario della regione ponto-caspica, classificato sia mediante l’analisi delle caratteristiche morfologiche della conchiglia che attraverso analisi genetiche e filogenetiche utilizzando il gene mitocondriale.
01 - Speciale
FEM e fauna d’acqua dolce
TRASFERIMENTO TECNOLOGICO
Dallo studio del ciclo biologico dei pesci ai corsi per pescatori
I percorsi di istruzione tecnica dell’Istituto Agrario prevedono, a partire dal terzo anno, la disciplina “Produzioni Animali” che, a seconda dell’indirizzo (Gestione Ambiente e Territorio, Produzioni e Trasformazioni, Viticoltura ed Enologia) viene declinata in contenuti strettamente connessi al corrispondente ambito professionale.
Nello specifico, alla tematica “Fauna ittica” è dedicata un’articolata trattazione nel triennio Gestione Ambiente e Territorio. In classe si apprendono la classificazione, l’anatomia e il ciclo biologico dei pesci e si affrontano alcuni aspetti specifici del nostro territorio: le specie ittiche, l’acquacoltura e la normativa vigente in Trentino; in laboratorio si osservano gli organi interni di alcune specie, al Centro di Trasferimento Tecnologico si visitano gli impianti ittici sperimentali.
Anche il percorso di Istruzione e Formazione Pro -
fessionale per tecnico imprenditore agricolo - indirizzo zootecnico- riserva un modulo all’itticoltura, con lezioni teoriche, condotte dai docenti e dai ricercatori e tecnologi della Fondazione, esercitazioni pratiche e studi di anatomia comparata, il tutto arricchito da visite formative alle pescicolture del territorio.
Questa modalità didattica è la dimostrazione di come a San Michele il sapere teorico si completi con le attività di laboratorio e la collaborazione con il mondo della ricerca e del lavoro.
Ma il Centro di Istruzione e Formazione non è solo scuola: dal 2011 ne fa parte anche l’Accademia Ambiente, Foreste e Fauna del Trentino che, in ambito ittico, propone numerose attività: i percorsi formativi propedeutici all’abilitazione all’esercizio della pesca in provincia di Trento (10 corsi all’anno, per un totale, al 31 dicembre 2022, di 101 corsi attivati e 6237 pescatori

formati), che si svolgono prevalentemente in modalità “Formazione a Distanza”, utilizzando un’apposita piattaforma online, e i percorsi formativi specifici, ovvero il Corso per Istruttore Ambientale di Pesca,

il Corso per Guida di Pesca, nato dalla collaborazione con Trentino Marketing per formare professionisti in grado di accompagnare e consigliare i turisti nelle esperienze di pesca, e il Corso Teorico Pratico di
Ittiologia, volto a fornire a studenti, liberi professionisti, tecnici e funzionari di enti le competenze fondamentali in ecologia fluviale, sistematica, morfologia e biologia dei pesci d’acqua dolce presenti sul territorio.
L’Accademia organizza inoltre incontri e workshop per sensibilizzare i pescatori o gli appassionati dell’ambiente acquatico sulle tematiche di maggiore attualità e partecipa a diversi eventi fieristici del settore.
Progetti di ricerca e sperimentazione per salvaguardare benessere e qualità dei prodotti di acquacoltura
Dai big data per gestire gli allevamenti ai mangimi sostenibili fino agli studi genetici
Negli ultimi anni le attività di sperimentazione nell’ambito dell’acquacoltura hanno visto la partecipazione di FEM a numerosi progetti a livello nazionale ed internazionale sul tema della nutrizione dei pesci, sul loro benessere in allevamento e sulla qualità dei prodotti di acquacoltura. Tra questi va citato il progetto SUSHIN, nel corso del quale sono stati studiati degli ingredienti innovativi per migliorare la sostenibilità economica e ambientale della produzione ittica nazionale.
Ulteriori studi sulla nutrizione riguardano l’effetto funzionale di vari ingredienti naturali addizionabili alla dieta della trota, dove per funzionale si intende la capacità, anche in piccole concentrazioni, di produrre dei benefici sul benessere generale del pesce. Tra questi annoveriamo olii essenziali derivati da piante aromatiche, i polifenoli presenti nel sottoprodotto della molitura delle olive, carotenoidi e omega-3 da alghe e microalghe.
Nell’ottica di uno sviluppo ecosostenibile dell’acquacoltura, grazie al progetto europeo GAIN, sono state studiate tecnologie di controllo avanzate degli allevamenti, quali monitoraggi real-time con sensori innovativi, sviluppo di modelli previsionali e gestione di Big Data, per permettere all’allevatore di migliorare in definitiva le proprie capacità di controllo e gestione dei processi, biologici e non, che avvengono nell’impianto.
Attualmente sono in corso progetti pluriennali riguardanti lo studio genetico della fauna ittica: le analisi genetiche su campioni di tessuto di ittiofauna nell’ambito del Progetto Europeo Life Graymarble Life 20, il progetto MarmoGen2 sulla genotipizzazione di trote (genere Salmo) dei principali corsi d’acqua altoatesini per il secondo triennio, l’iniziativa GenBAP sul monitoraggio genetico della Trota marmorata nei bacini dell’Adige, del Brenta e del Piave e il progetto FISHGen, che riguarda la genotipizzazione della fauna ittica di interesse conservazionistico dei principali corsi e specchi d’acqua altoatesini. Altri studi, nell’ambito dell’economia circolare, riguardano la valorizzazione di sottoprodotti delle produzioni agro-industriali, i quali, attraverso processi di trasformazione sia naturali che artificiali, possono essere riutilizzati nell’allevamento anziché essere eliminati come rifiuti. E’ l’obiettivo del progetto Win4Feed, in corso di svolgimento, che permette agli scarti di un processo produttivo di diventare risorse per un altro, contribuendo a generare sempre meno rifiuti.
Vanno citate in questa sede anche le attività svolte in passato, finalizzate allo sviluppo e al miglioramento delle metodiche di allevamento di specie quali il salmerino alpino e il carpione del Garda per il rilancio della produzione di queste specie di nicchia.
02 - Speciale FEM e fauna d’acqua dolce
Le attività di istruzione e formazione e i corsi erogati dall’Accademia Ambiente Foreste Fauna del Trentino
Supplemento a Terra di Mach n. 16
- Marzo 2023. Direttore responsabile Silvia Ceschini - Hanno collaborato: Adriano Boscaini, Maria Cristina Bruno, Erica Candioli, Maria Beatrice Cappelletti, Cristina Cappelletti, Stefano Casari, Silvia Ceschini, Francesca Ciutti, Andrea Gandolfi, Matteo Girardi, Emanuele Eccel, Filippo Faccenda, Martina Facchinelli, Davide Gabardi, Floriana Marin, Stefano Menapace, Ulrike Obertegger, Nico Salmaso, Monica Tolotti, Ettore Zanon - Fotografie: Archivio FEM e G. Cavulli. Chiuso in redazione 18 marzo 2023. LOGO FSC